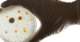
Genetically engineered bacteria make living materials for self-repairing walls and cleaning up pollution

With just an incubator and some broth, researchers can grow reusable filters made of bacteria to clean up polluted water, detect chemicals in the environment and protect surfaces from rust and mold.
I am a synthetic biologist who studies engineered living materials – substances made from living cells that have a variety of functions. In my recently published research, I programmed bacteria to form living materials that can not only be modified for different applications, but are also quick and easy to produce.
From living cells to usable materials
Like human cells, bacteria contain DNA that provides the instructions to build proteins. Bacterial DNA can be modified to instruct the cell to build new proteins, including ones that don’t exist in nature. Researchers can even control exactly where these proteins will be located within the cell.
Because engineered living materials are made of living cells, they can be genetically engineered to perform a broad variety of functions, almost like programming a cellphone with different apps. For example, researchers can turn bacteria into sensors for environmental pollutants by modifying them to change color in the presence of certain molecules. Researchers have also used bacteria to create limestone particles, the chemical used to make Styrofoam and living photovoltaics, among others.
A primary challenge for engineered living materials has been figuring out how to induce them to produce a matrix, or substances surrounding the cell, that allows researchers to control the physical properties of the final material, such as its viscosity, elasticity and stiffness. To address this, my team and I created a system to encode this matrix in the bacteria’s DNA.
We modified the DNA of the bacteria Caulobacter crescentus so that the bacterial cells would produce on their surfaces a matrix made of large amounts of elastic proteins. These elastic proteins have the ability to bind to each other and form hydrogels, a type of material that can retain large amounts of water.
When two genetically modified bacterial cells come in close proximity, these proteins come together and keep the cells attached to each other. By surrounding each cell with this sticky, elastic material, bacterial cells will cluster together to form a living slime.
Furthermore, we can modify the elastic proteins to change the properties of the final material. For example, we could turn bacteria into hard construction materials that have the ability to self-repair in the event of damage. Alternatively, we could turn bacteria into soft materials that could be used as fillers in products.
The living material advantage
Usually, creating multifunctional materials is extremely difficult, due in part to very expensive processing costs. Like a tree growing from a seed, living materials, on the other hand, grow from cells that have minimal nutrient and energy requirements. Their biodegradability and minimal production requirements allow for sustainable and economical production.
The technology to make living materials is unsophisticated and cheap. It only takes a shaking incubator, proteins and sugars to grow a multifunctional, high-performing material from bacteria. The incubator is just a metal or plastic box that keeps the temperature at about 98.6 degrees Fahrenheit (37 Celsius), which is much lower than a conventional home oven, and shakes the cells at speeds slower than a blender.
Transforming bacteria into living materials is also a quick process. My team and I were able to grow our bacterial living materials in about 24 hours. This is pretty fast compared to the manufacturing process of other materials, including living materials like wood that can take years to produce.
Moreover, our living bacterial slime is easy to transport and store. It can survive in a jar at room temperature for up to three weeks and placed back into a fresh medium to regrow. This could lower the cost of future technology based on these materials.
Lastly, engineered living materials are an environmentally friendly technology. Because they are made of living cells, they are biocompatible, or nontoxic, and biodegradable, or naturally decomposable.
Next steps
There are still some aspects of our bacterial living material that need to be clarified. For example, we don’t know exactly how the proteins on the bacterial cell surface interact with each other, or how strongly they bind to each other. We also don’t know exactly how many protein molecules are required to keep cells together.
Answering these questions will enable us to further customize living materials with desired qualities for different functions.
Next, I’m planning to explore growing different types of bacteria as living materials to expand the applications they can be used for. Some types of bacteria are better than others for different purposes. For example, some bacteria survive best in specific environments, such as the human body, soil or fresh water. Some, on the other hand, can adapt to different external conditions, like varying temperature, acidity and salinity.
By having many types of bacteria to choose from, researchers can further customize the materials they can create.
Sara Molinari, Postdoctoral Research Associate in Synthetic Biology, Rice University
This article is republished from The Conversation under a Creative Commons license. Read the original article.